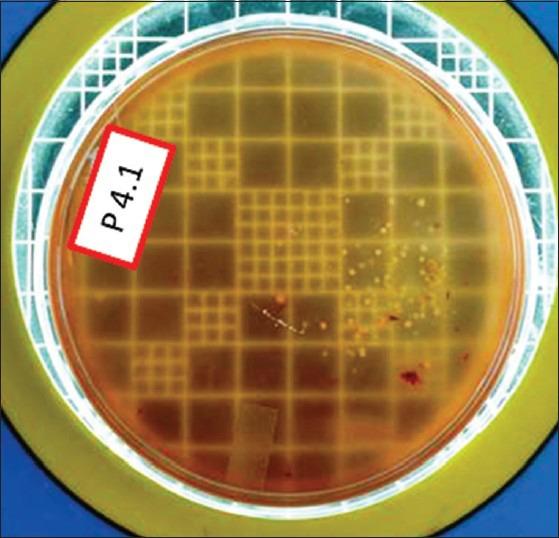
https://cdn.ncbi.nlm.nih.gov/pmc/blobs/a4c4/4374313/d9b78d6dc292/CCD-6-24-g010.jpg

微创牙科中的窝洞消毒——芦荟与蜂胶的比较评价:一项随机临床试验
Cavity disinfection in minimally invasive dentistry - comparative evaluation of Aloe vera and propolis: A randomized clinical trial.
作者信息
Prabhakar A R, Karuna Y M, Yavagal C, Deepak B M
机构信息
Department of Pedodontics and Preventive Dentistry, Bapuji Dental College and Hospital, Davangere, Karnataka, India.
出版信息
Contemp Clin Dent. 2015 Mar;6(Suppl 1):S24-31. doi: 10.4103/0976-237X.152933.
CONTEXT
The survival of atraumatic restorative treatment (ART) restorations would probably increase if near total elimination of cariogenic microorganisms could be done in the process of cavity cleaning before going ahead with the restoration. Thus, use of naturally occurring disinfecting agents for achieving this goal could herald a new beginning in the field of contemporary minimum intervention dentistry.
AIMS
To evaluate the efficacy of hand instruments in excavating dental caries and comparatively evaluate the roles of Aloe vera and propolis as potential cavity disinfecting agents after minimally invasive hand excavation of dental caries.
SETTINGS AND DESIGNS
Experimental, in vivo intergroup split mouth, randomized clinical trial.
SUBJECTS AND METHODS
The study included Group I (Control), Group II (A. vera) and Group III (propolis). Ten patients with three teeth each have occlusal/occlusoproximal lesions suitable for ART were selected. Dentinal samples were collected three times from each tooth viz., preexcavation, postexcavation and postdisinfection of the cavities. These dentinal samples were subjected to microbiological analyses for total viable count.
STATISTICAL ANALYSIS USED
Repeated measures of analysis of variance (ANOVA) with Bonferroni post-hoc test and one-way ANOVA with Tukey post-hoc test.
RESULTS
In all the three groups, significant amount of bacteria were left behind after hand excavation. Group II and Group III, in which cavities were treated with A. vera and propolis extracts respectively, showed a significant reduction in the bacterial counts when compared to control the group.
CONCLUSIONS
Hand excavation alone does not completely eliminate bacteria, which may predispose treated teeth to secondary caries. Both propolis and A. vera extracts can be used as potential natural disinfecting agents, thereby embracing the concept of phytotherapy in minimum intervention dentistry.
背景
如果在进行修复之前的窝洞清洁过程中能够几乎完全消除致龋微生物,非创伤性修复治疗(ART)修复体的存留率可能会提高。因此,使用天然消毒剂来实现这一目标可能会开创当代微创牙科领域的新局面。
目的
评估手动器械在龋洞挖掘中的效果,并在微创手动挖掘龋洞后,比较芦荟和蜂胶作为潜在窝洞消毒剂的作用。
设置与设计
实验性、体内组间分口、随机临床试验。
研究对象与方法
该研究包括第一组(对照组)、第二组(芦荟组)和第三组(蜂胶组)。选择10名患者,每人有3颗适合ART治疗的咬合面/咬合邻面病变牙齿。从每颗牙齿的窝洞挖掘前、挖掘后和消毒后三个时间点采集牙本质样本。对这些牙本质样本进行微生物分析,以检测总活菌数。
统计分析方法
采用重复测量方差分析(ANOVA)及Bonferroni事后检验,以及单因素方差分析及Tukey事后检验。
结果
在所有三组中,手动挖掘后仍残留大量细菌。分别用芦荟提取物和蜂胶提取物处理窝洞的第二组和第三组,与对照组相比,细菌计数显著降低。
结论
仅手动挖掘并不能完全消除细菌,这可能会使治疗后的牙齿易患继发龋。蜂胶和芦荟提取物都可作为潜在的天然消毒剂,从而在微创牙科中引入植物疗法的概念。